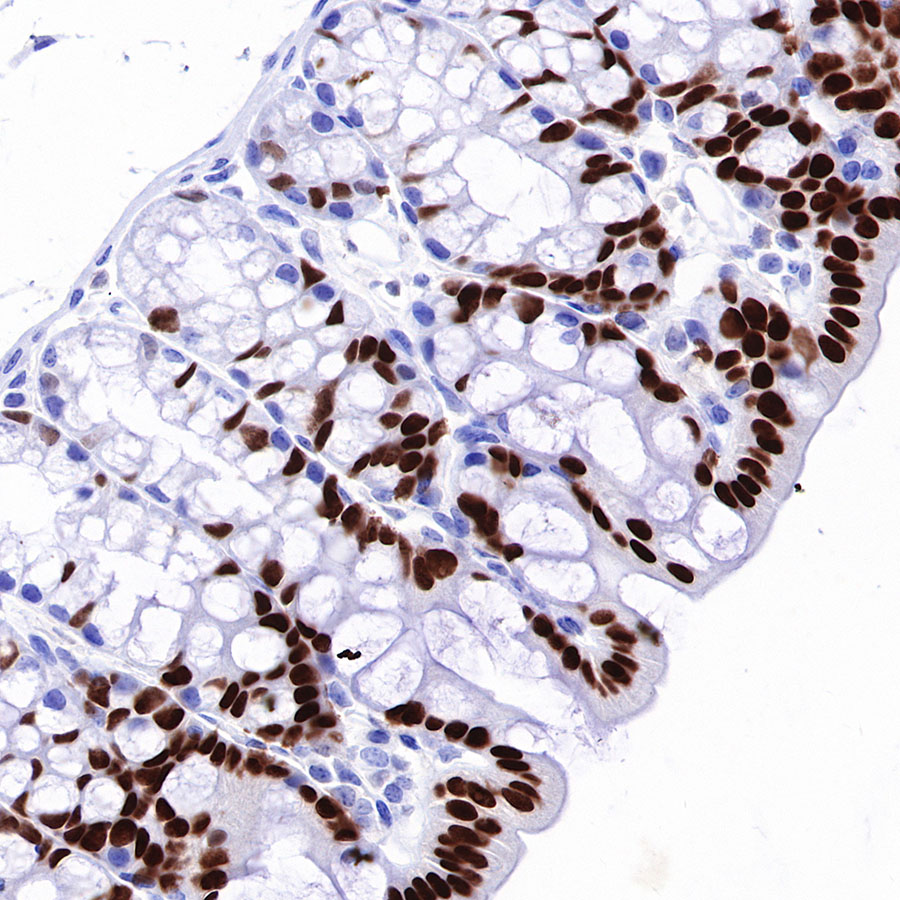

Product Details
Product Details
Product Specification
Host | Rabbit |
Antigen | HNF4α |
Synonyms | Hepatocyte nuclear factor 4, NR2A1, HNF-4-alpha, HNF-4, TCF-14 |
Immunogen | Recombinant Protein |
Location | Nucleus |
Accession | P49698 |
Clone Number | SDT-373-64 |
Antibody Type | Recombinant mAb |
Application | WB, IHC-P, ICC, IP, ICFCM |
Reactivity | Hu, Ms, Rt |
Purification | Protein A |
Concentration | 0.5 mg/ml |
Physical Appearance | Liquid |
Storage Buffer | PBS, 40% Glycerol, 0.05% BSA, 0.03% Proclin 300 |
Stability & Storage | 12 months from date of receipt / reconstitution, -20 °C as supplied |
Dilution
application | dilution | species |
WB | 1:1000 | |
IHC-P | 1:500 | |
ICC | 1:500 | |
IP | 1:50 | |
ICFCM | 1:500 |
Background
HNF4α is a transcription factor that plays an important role in liver morphogenesis and maintenance of proper hepatocyte function in a mature liver. Most liver diseases have been associated with altered HNF4α expression, isoform ratios, and localization. Therefore, many studies have indicated that HNF4α may potentially be a target gene for the regression of fibrosis and cirrhosis [PMID: 35114889].
Picture
Picture
Western Blot

FC

Flow cytometric analysis of 4% PFA fixed 90% methanol permeabilized HeLa (Left) / HepG2 (Right) cells labelling HNF4α antibody at 1/500 dilution (0.1 μg)/ (Red) compared with a Rabbit monoclonal IgG (Black) isotype control and an unlabelled control (cells without incubation with primary antibody and secondary antibody) (Blue). Goat Anti-Rabbit IgG Alexa Fluor® 488 was used as the secondary antibody. Negative control: HeLa
IP

HNF4α Rabbit mAb at 1/50 dilution (1 µg) immunoprecipitating HNF4α in 0.4 mg HepG2 whole cell lysate.
Western blot was performed on the immunoprecipitate using HNF4α Rabbit mAb at 1/1000 dilution.
Secondary antibody (HRP) for IP was used at 1/400 dilution.
Lane 1: HepG2 whole cell lysate 20 µg (Input)
Lane 2: HNF4α Rabbit mAb IP in HepG2 whole cell lysate
Lane 3: Rabbit monoclonal IgG IP in HepG2 whole cell lysate
Predicted MW: 53 kDa
Observed MW: 45~55 kDa
Exposure time: 20 s
Immunohistochemistry

Immunocytochemistry












